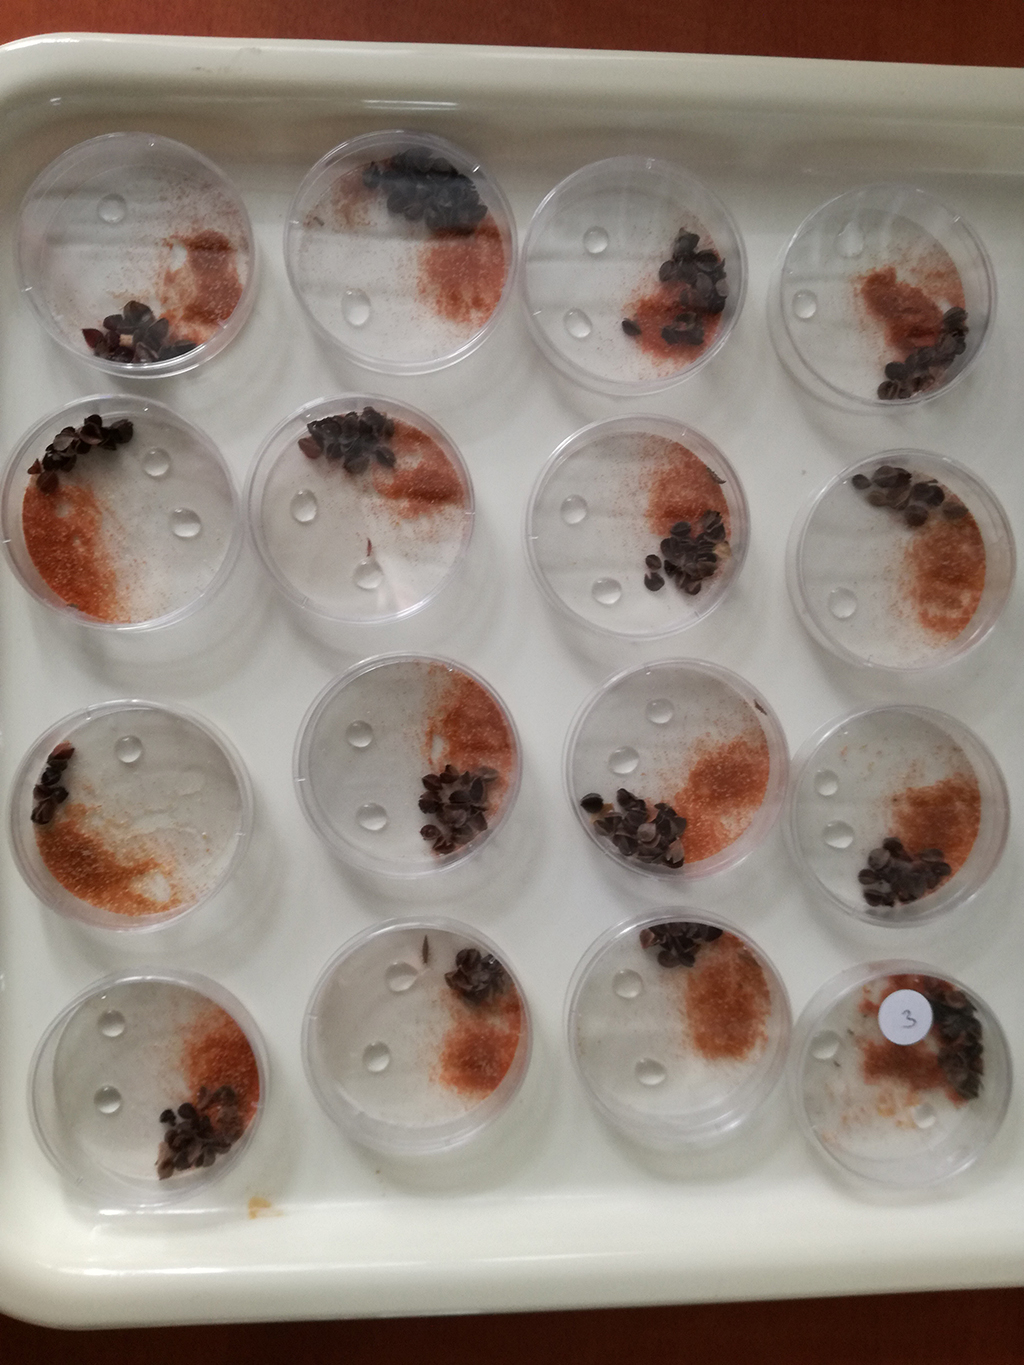

Biotecnologie: ENEA studia il possibile impiego di nuovi bioinsetticidi in agricoltura biologica

I ricercatori del Centro ENEA di Trisaia, in Basilicata, stanno studiando l’impatto ambientale dei biopesticidi di nuova generazione in grado di “silenziare” specifici geni degli insetti che causano danni alle coltivazioni. Condotta nell’ambito del progetto europeo “iPlanta”, coordinato dall’Università Politecnica delle Marche, questa ricerca prevede test sull’interazione tra gli insetti trattati con l’innovativo biopesticida e i loro predatori naturali utilizzati nella lotta integrata, che è un tipo di agricoltura caratterizzato da una drastica riduzione di fitofarmaci.
Questi nuovi bioinsetticidi sono basati sulla tecnica detta “RNAi” (RNA-interferente), che sfrutta un meccanismo naturale presente in organismi vegetali e animali per portare alla perdita di funzionalità di un gene bersaglio, fondamentale per la sopravvivenza o la fertilità dell’insetto.
«Fin dalla sua coperta nel 1998, l’RNAi ha catturato l’attenzione dei ricercatori per le sue potenzialità nel controllo di parassiti e di malattie in agricoltura. Una risposta positiva al biopesticida è stata riscontrata, ad esempio, nella “dorifora della patata”, l’insetto che rappresenta la principale minaccia per le coltivazioni di questo tubero», aggiunge Arpaia.
Le ricerche ENEA si stanno concentrando su un insetto predatore come la Chrysoperla carnea, comunemente chiamato crisopa, che rappresenta uno dei principali “nemici” degli insetti dannosi per colture come piante da frutto, fragole e ortaggi.
«Dai primi test effettuati non abbiamo riscontrato effetti negativi sulla crisopa quando entra in contatto con i biopesticidi RNAi, aprendo la strada a un loro possibile uso anche in agricoltura biologica», sottolinea Arpaia.
Oltre ai biopesticidi in agricoltura, la tecnica dell’RNAi potrebbe rivelarsi utile anche nel risanamento ambientale. «Insieme all’Università di Atene testeremo questa biotecnologia sulle piante per renderle in grado di assorbire inquinanti dal suolo oltre il loro limite naturale. Questo permetterebbe di bonificare i terreni da metalli tossici come arsenico e cadmio. Si tratta di piante non destinate all’alimentazione umana o animale, ma che, una volta raccolte, potrebbero essere utilizzate nella produzione di energia e biocarburanti», conclude Arpaia.
Il progetto “iPlanta” è finanziato nell’ambito di COST (European Cooperation in Science and Technology), l’organizzazione intergovernativa che finanzia progetti quadriennali, detti Azioni (Action), per la creazione di reti di ricerca tra scienziati europei e di altri paesi.
clicca e scopri come sostenerci








